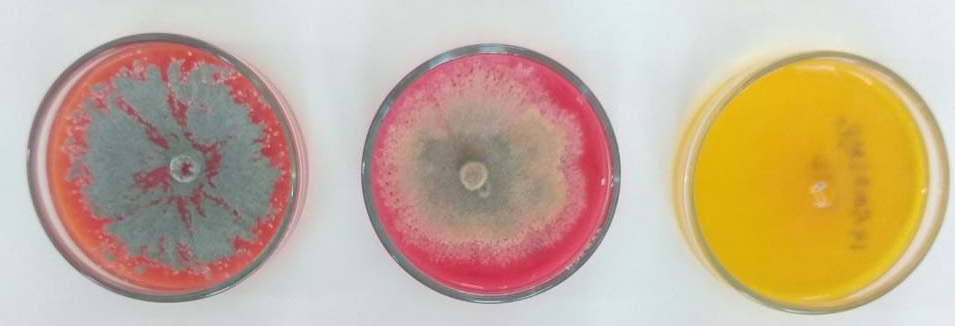

Pesquisa realizada por professor da Ufal usa amostras ambientais coletadas no continente.
Em uma expedição de dois meses, um biólogo e professor do Campus Arapiraca da Universidade Federal de Alagoas (Ufal) foi à Antártica para para coletar microrganismos que deverão fazer parte de seus estudos.
Entre novembro e dezembro de 2022, Alysson Wagner Fernandes Duarte coletou amostras ambientais de solos, liquens e vegetação para o isolamento de microrganismos.
O material coletado na expedição Operantar XLI será utilizado para avaliar o potencial de aplicação biotecnológica na área da saúde humana e no setor agrícola, segundo o pesquisador.
“O que fazemos durante a expedição é essencialmente coletar amostras ambientais, trazê-las congeladas ao Brasil e fazer o processamento das amostras na Ufal”, explica.

De acordo com Alysson, por estarem em um local com condições ambientais extremas, os microrganismos que sobrevivem na Antártica precisam se adaptar às condições adversas, podendo produzir compostos com novas propriedades e aplicações.
Alysson Duarte destaca os resultados desse esforço para o desenvolvimento da pesquisa na Ufal. “Como dizemos, a Antártica é um laboratório natural devido às condições ambientais extremas. Tem características limitantes para a sobrevivência de todas as formas de vida, com as menores temperaturas da Terra, além de extremos de radiação ultravioleta UV-A, UV-B, ciclos de congelamento e degelo e estresse hídrico”, ressalta o pesquisador.
Além disso, a pesquisa da microbiologia Antártica realizou um estudo similar com a Caatinga de Alagoas. “Apesar de distantes, são ambientes com características similares como o estresse hídrico, a Antártica sendo um deserto frio e a Caatinga um deserto quente. Os dois últimos editais de pesquisa que aprovamos, no CNPq e Fapeal, foram com essa perspectiva, a de aproximar esses ambientes distantes através da avaliação do potencial biotecnológico dos microrganismos isolados deles”, completa.
Microrganismos podem ser fontes de recursos biológicos para vários usos
Ainda de acordo com o pesquisador, o estudo é voltado para a produção de enzimas por leveduras de líquens da Antártica. As principais linhas de frente pesquisadas nos microrganismos da Antártica são: prospecção de enzimas, produção e avaliação de pigmentos microbianos e aplicação agrícola.
“Temos trabalhado com produção de enzimas, pigmentos, aplicação agrícola e atividade contra Leishmania, em parceria com as professoras Magna Moreira e Aline C. de Queiroz, dos campi da Ufal em Maceió e Arapiraca, respectivamente”, salienta Alysson.
O professor destaca, ainda, que as pesquisas no continente podem ser variadas, e que os microrganismos representam novas fontes de recursos biológicos para diferentes usos pelo ser humano, podendo entrar na área da saúde ou no setor agrícola.
“Por fim, estudar a Antártica é importante para alertamos para a preservação do ambiente, visando conscientizar a população da riqueza biológica que existe naquele continente”, finaliza Alysson.


Programa Antártico Brasileiro
O Programa Antártico Brasileiro, responsável pela expedição, é coordenado pela Marinha do Brasil, Ministério de Ciência, Tecnologia e Inovação (MCTI) e CNPq, além de participação de várias universidades brasileiras, e existe há 41 anos.
Alysson ficou na Estação Antártica Comandante Ferraz (EACF) e fez as coletas na ilha Rei George. Inaugurada em 2020, a nova Estação Antártica Brasileira é a 3ª maior estação científica do mundo na Antártica, sendo referência em infraestrutura.
“A estação tem uma capacidade de geração de energia renovável e uma estrutura de excelência. Fiquei feliz em ter visto essa nova estação. Quando estive lá, em 2017, a equipe chinesa estava construindo a estação. Vê-la pronta, do jeito como ficou, é muito animador”, diz o pesquisador.


Pesquisas desenvolvidas relacionadas à coleta de amostras
- Prospecção de enzimas:
Publicado em 2022, na edição especial de tema Antártico nos Anais da Academia Brasileira de Ciências, a pesquisa reporta diferentes espécies de leveduras com versatilidade na produção de proteases, amilases, pectinases.
O estudo aponta que as enzimas podem ser utilizadas na indústria de alimentos, produção de fármacos, combustíveis, entre outros.
“Buscamos enzimas que tenham atividade fibrinolítica e que possam ser aplicadas na saúde humana, como no tratamento de trombose. Além disso, temos pesquisado a produção de L-asparaginase por fungos da Antártica e a principal aplicação dessa enzima é a aplicação no tratamento da Leucemia Linfoblástica Aguda”.
O estudo pode ser lido aqui.
- Produção e avaliação de pigmentos microbianos:
Como um dos fatores de estresse no Polo Sul é o excesso de luz UV, alguns microrganismos produzem pigmentos como se fosse uma resposta de adaptação a esta condição e ao frio do ambiente. O artigo foi publicado em 2021, na revista Critical Review in Biotechnology.
O estudo reporta os pigmentos bacterianos por isolados da Antártica e destaca isolados vermelhos resistentes a altas doses de UV-C. A pesquisa mostra que é possível produzir e extrair esses pigmentos e utilizar para aplicações cosméticas, por exemplo, se tornando uma alternativa de corante natural para o setor, que busca substituir os compostos sintéticos.
“Também estamos estudando se estes pigmentos têm atividade antimicrobiana, antioxidante ou contra a Leishmania. Este último em colaboração com as professoras Magna e Aline, que são referência na busca de fármacos com atividade leishmanicida” , explica Alysson.
A pesquisa completa está disponível neste link.
- Aplicação agrícola:
Uma análise envolvendo a utilização de fungos e bactérias da Antártica como bio-inoculantes solubilizadores de fosfato inorgânico está sendo feita.
De acordo com Alysson, o fósforo solúvel é uma das necessidades do setor agrícoola, mas não é suficiente apenas o produtor adicionar o adubo químico (fósforo) aos solos, já que a maior parte dele ficará inacessível às plantas.
“Os micro-organismos solubilizadores de fosfato é que fazem a solubilização deste elemento químico para a raiz da planta e vimos que tanto as bactérias quanto as leveduras da Antártica apresentam uma boa atividade de solubilização de fosfato”, explica.
É possível saber mais sobre os estudos aqui e aqui.